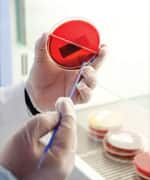
Reverse Active Liver Damage

Life Extension Magazine®

The liver is responsible for more than 500 vital life functions.1
Few people realize how critical liver function is to all aspects of health.1
Our liver works tirelessly as a purification plant to eliminate cellular waste products such as ammonia, as well as environmental toxins like heavy metals, pollutants, and drugs.1
Just as important, our liver helps regulate glucose/cholesterol blood levels, breaks down fats in our digestive tract, regulates blood clotting and converts foods into forms easier to use for the rest of the body. Our liver also helps detoxify dietary carcinogens.1
Disorders ranging from cirrhosis to non-alcoholic fatty liver disease and even cancer can increase oxidative stress in the liver resulting in liver damage and impairment of function.2-6
For more than 2,000 years, milk thistle has been used to treat liver as well as gall bladder dysfunction.7 Studies confirm that milk thistle can protect liver function, prevent liver damage, and normalize elevated liver enzyme levels.8-10
Specific compounds within milk thistle are responsible for its potent liver-protecting benefits.11 The exciting news is that, researchers have discovered a way to make milk thistle far more effective.
In recent developments, scientists have created a method to provide close to five times more of milk thistle’s bioactive compound into your bloodstream.12
As a result of this enhancement, you can now get up to 10 times more benefit directly to your liver from a single dose of milk thistle extract. The result is unprecedented protection for an aging liver.13,14
The Key to Unlocking Milk Thistle’s Benefits
Extracts from the milk thistle (Silybum marianum) have been used for centuries for their preventive and curative properties for liver disease.7,9 One of the most beneficial milk thistle components responsible for these protective effects is called silymarin.9,11
A potent antioxidant and anti-inflammatory, silymarin helps fight the root causes of liver disease.15-19 Further research has identified a molecule called silybin as being the most active component in silymarin.9,20
As beneficial as milk thistle is, there’s one issue keeping it from reaching its fullest potential: silybin has poor bioavailability, meaning it’s difficult for your body to absorb.12-14,21,22
But scientists have now developed a novel way to overcome silybin’s poor bioavailability. The solution is to combine silybin with a nutrient called phosphatidylcholine.23
As a major component of cell membranes, phosphatidylcholine facilitates transport across the cells lining the intestines, making it an ideal “carrier molecule” for silybin.21-23
Close to 5 Times Better Absorption!
When silybin is combined with phosphatidylcholine, it is absorbed nearly 5 times better than silymarin alone, and its concentration to the liver is 10-fold greater than silymarin alone.12-14
In a study of rats exposed to various liver toxins, the combination of silybin plus phosphatidylcholine protected against the telltale rise in plasma levels of liver enzymes (a marker of liver damage), while the same doses of either nutrient alone had no detectable effect.8
Human studies also demonstrated that this complex has better results than silymarin or silybin alone, lowering serum levels of liver enzymes and producing clinical improvement in studies of liver cirrhosis and hepatitis caused by alcohol, drugs, and viruses.22
Reverse Alcohol-Induced Liver Damage
You likely already know that large amounts of alcohol impose extreme oxidative stress on liver tissue,2,19 but what you might not know is that milk thistle compounds have the potential to attenuate and even reverse alcohol-induced liver damage.2,19,22
In animal studies, acute alcohol administration produced a number of destructive effects in the liver, including prominent accumulations of fat in liver cells, small areas of dead tissue (necrosis), a rise in liver enzymes in the blood, a reduction in glutathione (the main intracellular antioxidant), and an increase in levels of the destructive cytokine TNF-alpha. Amazingly, supplementing with silymarin prevented all of these adverse alcohol-induced changes.19
And one dramatic human study demonstrated just how powerfully silymarin protects liver activity and improves liver function in alcoholic patients.24 In a double-blind, clinical trial of 36 people with chronic alcoholic liver disease, patients took either silymarin or placebo every day for six months.24 At baseline, all patients had elevated liver enzymes and other markers of liver damage in their blood; they also had biopsy-proven tissue damage.
Following treatment, however, all of the markers of liver damage had normalized in the silymarin group (with only minimal changes among placebo recipients).24 Even better, subsequent biopsies indicated reversal of the disease process by revealing cellular-level improvement in the silymarin group, but no changes in the placebo patients.
Milk Thistle Outperforms Mainstream Treatment
Although non-alcoholic fatty liver disease (NAFLD) is the most common cause of chronic liver disease in industrialized nations, mainstream medicine has little to offer for those suffering from this disease.25,26 Fortunately, silymarin holds out substantial promise.4,27
In a 2012 study, researchers compared silymarin (140 mg/day) with insulin sensitizing drugs like metformin and pioglitazone.27 All three treatments produced improvements in fasting blood sugar, lipid profiles, insulin levels, and insulin resistance, along with decreases in blood levels of liver enzymes. However, the silymarin group experienced the greatest decrease in liver enzymes, indicating greater protection against liver damage.27
As promising as silybin is on its own, the increased bioavailability of silybin in combination with phosphatidylcholine represents a major step forward in managing non-alcoholic fatty liver disease. One early study of patients with non-alcoholic fatty liver disease showed significant reductions in plasma markers of liver fibrosis and significant improvements in insulin resistance, using a combination of silybin, vitamin E, and phospholipids.28
A more recent, larger trial of a unique combination of silybin with phosphatidylcholine and vitamin E demonstrated significant improvements in liver enzymes, insulin resistance, and the appearance of liver tissue on biopsy (none of which were seen in placebo recipients).10
Restore Vital Liver Function
In about 10% of cases, non-alcoholic fatty liver disease progresses to non-alcoholic steatohepatitis (NASH), a dangerous condition that ultimately produces liver fibrosis, cirrhosis, and even cancer.29,30
Silybin has been shown to restore vital liver functions in animals with non-alcoholic steatohepatitis, improving insulin sensitivity and markers of oxidative and inflammatory damage.31,32
It also suppressed the transformation of normal liver structural cells into the tough, inelastic tissue characteristic of liver fibrosis and cirrhosis, the end-stage phases of liver disease that follows non-alcoholic steatohepatitis.33
Reverse Active Liver Damage
Viral hepatitis is a catch-all phrase for infections (such as hepatitis B and C) that can cause liver damage and raise the risk for liver cancer. Both hepatitis B and C can set up chronic infection (chronic active hepatitis) that can progress to fibrosis and cirrhosis.34
Silymarin treatment in acute viral hepatitis can speed the normalization of liver enzymes in the blood, indicating a regression of active liver damage.35
A group of patients with chronic active hepatitis took 240 mg of silybin combined with phosphatidylcholine, or placebo, twice daily for 7 days.36 The patients taking silybin had significant drops in all markers of liver damage, while control patients experienced no changes.36
While effective against hepatitis-induced liver damage, oral silymarin produces no reduction in the number of viral particles infecting the body, but studies of silymarin given intravenously reveal a substantial antiviral effect in patients who have not responded to standard IV antiviral treatment.35,37
Increased Survival Rates!
Those with cirrhosis, the end-stage result of liver damage, are faced with two options: a slow and uncomfortable death or a liver transplant.38 Fortunately, milk thistle extracts have been found to increase the survival rate of this deadly condition.
One study found that in people with alcohol-induced cirrhosis, those taking silymarin survived longer than control subjects.39 A later study confirmed that finding, with 58% of silymarin-treated patients surviving longer than 4 years, compared with 39% of the placebo group.40
Even when liver disease has reached the stage of cirrhosis, silymarin treatment can normalize elevated liver enzymes in the blood, indicating that it has slowed the progression of liver damage.41
Summary
Milk thistle extract has now been proven to lessen and, in some cases, reverse liver damage. Studies have shown that it can benefit multiple liver disorders, including alcohol-induced liver damage, non-alcoholic fatty liver disease, non-alcoholic steatohepatitis, viral infections, and cirrhosis.2,4,19,22,26,30,31,34,38-40
Scientists have uncovered specific compounds in milk thistle responsible for its liver-promoting benefits—and in the process have uncovered a way to substantially increase their absorption and bioavailability.13,14 This breakthrough improves the delivery of the benefits of milk thistle extracts for liver health.
If you have any questions on the scientific content of this article, please call a Life Extension® Health Advisor at 1-866-864-3027.
Editor's Note
Science continues to evolve, and new research is published daily. As such, we have a more recent article on this topic: Milk Thistle Promotes Liver Detoxification
References
- Available at: http://health.nytimes.com/health/guides/disease/alcoholic-liver-disease/print.html. Accessed August 19, 2013.
- Velussi M, Cernigoi AM, De Monte A, Dapas F, Caffau C, Zilli M. Long-term (12 months) treatment with an anti-oxidant drug (silymarin) is effective on hyperinsulinemia, exogenous insulin need and malondialdehyde levels in cirrhotic diabetic patients. J Hepatol. 1997 Apr;26(4):871-9.
- Marra M, Sordelli IM, Lombardi A, et al. Molecular targets and oxidative stress biomarkers in hepatocellular carcinoma: an overview. J Transl Med. 2011 Oct 10;9:171.
- Yao J, Zhi M, Minhu C. Effect of silybin on high-fat-induced fatty liver in rats. Braz J Med Biol Res. 2011 Jul;44(7):652-9.
- Videla LA, Rodrigo R, Orellana M, et al. Oxidative stress-related parameters in the liver of non-alcoholic fatty liver disease patients. Clin Sci (Lond). 2004 Mar;106(3):261-8.
- Paracha UZ, Fatima K, Alqahtani M, et al. Oxidative stress and hepatitis C virus. Virol J. 2013 Aug 7;10(1):251. [Epub ahead of print]
- Available at: http://www.cancer.gov/cancertopics/pdq/cam/milkthistle/patient/page1/allpages/print. Accessed July 17, 2013.
- Conti M, Malandrino S, Magistretti MJ. Protective activity of silipide on liver damage in rodents. Jpn J Pharmacol. 1992 Dec;60(4):315-21.
- Available at: http://www.thorne.com/altmedrev/.fulltext/4/4/272.pdf. Accessed July 17, 2013.
- Loguercio C, Andreone P, Brisc C, et al. Silybin combined with phosphatidylcholine and vitamin E in patients with nonalcoholic fatty liver disease: a randomized controlled trial. Free Radic.Biol Med. 2012;52(9):1658-65.
- Abenavoli L, Capasso R, Milic N, Capasso F. Milk thistle in liver diseases: past, present, future. Phytother Res. 2010 Oct;24(10):1423-32.
- Barzaghi N, Crema F, Gatti G, Pifferi G, Perucca E. Pharmacokinetic studies on IdB 1016, a silybin- phosphatidylcholine complex, in healthy human subjects. Eur J Drug Metab Pharmacokinet. 1990;15(4):333-38.
- Morazzoni P, Magistretti MJ, Giachetti C, Zanolo G. Comparative bioavailability of silipide, a new flavanolignan complex, in rats. Eur J Drug Metab Pharmacokinet. 1992 Jan-Mar;17(1):39-44.
- Morazzoni P, Montalbetti A, Malandrino S, Pifferi G. Comparative pharmacokinetics of silipide and silymarin in rats. Eur J Drug Metab Pharmacokinet. 1993 Jul-Sep;18(3):289-97.
- Par A, Roth E, Miseta A, et al. Effects of supplementation with the antioxidant flavonoid, silymarin, in chronic hepatitis C patients treated with peg-interferon + ribavirin. A placebo-controlled double blind study. Orv Hetil. 2009 Jan 11;150(2):73-9.
- Zhu HJ, Brinda BJ, Chavin KD, Bernstein HJ, Patrick KS, Markowitz JS. An assessment of pharmacokinetics and antioxidant activity of free silymarin flavonolignans in healthy volunteers: A dose escalation study. Drug Metab Dispos. 2013 Jul 8. [Epub ahead of print]
- Ramasamy K, Agarwal R. Multitargeted therapy of cancer by silymarin. Cancer Lett. 2008 Oct 8;269(2):352-62.
- Ravichandran K, Velmurugan B, Gu M, Singh RP, Agarwal R. Inhibitory effect of silibinin against azoxymethane-induced colon tumorigenesis in A/J mice. Clin Cancer Res. 2010 Sep 15;16(18):4595-606.
- Song Z, Deaciuc I, Song M, et al. Silymarin protects against acute ethanol-induced hepatotoxicity in mice. Alcohol Clin Exp Res. 2006 Mar;30(3):407-13.
- Fan S, Yu Y, Qi M, et al. P53-mediated GSH depletion enhanced the cytotoxicity of NO in silibinin-treated human cervical carcinoma HeLa cells. Free Radic Res. 2012 Sep;46(9):1082-92.
- Kidd P Fau - Head K, Head K. A review of the bioavailability and clinical efficacy of milk thistle phytosome: a silybin-phosphatidylcholine complex (Siliphos). Altern Med Rev. 2005 Sep;10(3):193-203.
- Kidd PM. Bioavailability and activity of phytosome complexes from botanical polyphenols: the silymarin, curcumin, green tea, and grape seed extracts. Altern Med Rev. 2009;14(3):226-46.
- Dixit N, Baboota S, Kohli K, Ahmad S, Ali J. Silymarin: A review of pharmacological aspects and bioavailability enhancement approaches. Indian J Pharmacol. 2007;39(4):172-79.
- Feher J, Deak G, Muzes G, et al. Liver-protective action of silymarin therapy in chronic alcoholic liver diseases. Orv Hetil. 1989 Dec 17;130(51):2723-7.
- Masuoka HC, Chalasani N. Nonalcoholic fatty liver disease: an emerging threat to obese and diabetic individuals. Ann N Y Acad Sci. 2013 Jan 30.
- Available at: http://www.mayoclinic.com/health/nonalcoholic-fatty-liver-disease/ds00577/dsection=treatments-and-drugs. Accessed August 21, 2013.
- Hajiaghamohammadi AA, Ziaee A, Oveisi S, Masroor H. Effects of metformin, pioglitazone, and silymarin treatment on non-alcoholic Fatty liver disease: a randomized controlled pilot study. Hepat Mon. 2012 Aug;12(8):e6099.
- Trappoliere M, Federico A, Tuccillo C, et al. Effects of a new pharmacological complex (silybin + vitamin-E + phospholipids) on some markers of the metabolic syndrome and of liver fibrosis in patients with hepatic steatosis. Preliminary study. Minerva Gastroenterol Dietol. 2005 Jun;51(2):193-9.
- Trappoliere M, Tuccillo C, Federico A, et al. The treatment of NAFLD. Eur Rev Med Pharmacol Sci. 2005 Sep-Oct;9(5):299-304.
- Hajiaghamohammadi AA, Ziaee A, Oveisi S, Masroor H. Effects of metformin, pioglitazone, and silymarin treatment on non-alcoholic fatty liver disease: a randomized controlled pilot study. Hepat Mon. 2012 Aug;12(8):e6099.
- Salamone F, Galvano F, Cappello F, Mangiameli A, Barbagallo I, Li Volti G. Silibinin modulates lipid homeostasis and inhibits nuclear factor kappa B activation in experimental nonalcoholic steatohepatitis. Transl Res. 2012 Jun;159(6):477-86.
- Salamone F, Galvano F, Marino Gammazza A, et al. Silibinin improves hepatic and myocardial injury in mice with nonalcoholic steatohepatitis. Dig Liver Dis. 2012 Apr;44(4):334-42.
- Kim M, Yang SG, Kim JM, Lee JW, Kim YS, Lee JI. Silymarin suppresses hepatic stellate cell activation in a dietary rat model of non-alcoholic steatohepatitis: analysis of isolated hepatic stellate cells. Int J Mol Med. 2012 Sep;30(3):473-9.
- Available at: http://www.cdc.gov/hepatitis/resources/professionals/pdfs/abctable.pdf. Accessed August 21, 2013.
- Magliulo E, Gagliardi B, Fiori GP. Results of a double blind study on the effect of silymarin in the treatment of acute viral hepatitis, carried out at two medical centres (author’s transl). Med Klin. 1978 Jul 14;73(28-29):1060-5.
- Buzzelli G, Moscarella S, Giusti A, Duchini A, Marena C, Lampertico M. A pilot study on the liver protective effect of silybin-phosphatidylcholine complex (IdB1016) in chronic active hepatitis. Int J Clin Pharmacol Ther Toxicol. 1993 Sep;31(9):456-60.
- Ferenci P, Scherzer TM, Kerschner H, et al. Silibinin is a potent antiviral agent in patients with chronic hepatitis C not responding to pegylated interferon/ribavirin therapy. Gastroenterology. 2008 Nov;135(5):1561-7.
- Available at: http://www.webmd.com/digestive-disorders/cirrhosis-liver. Accessed August 21, 2013.
- Benda L, Dittrich H, Ferenzi P, Frank H, Wewalka F. The influence of therapy with silymarin on the survival rate of patients with liver cirrhosis (author’s transl). Wien Klin Wochenschr. 1980 Oct 10;92(19):678-83.
- Ferenci P, Dragosics B, Dittrich H, et al. Randomized controlled trial of silymarin treatment in patients with cirrhosis of the liver. J Hepatol. 1989 Jul;9(1):105-13.
- Lang I, Nekam K, Deak G, et al. Immunomodulatory and hepatoprotective effects of in vivo treatment with free radical scavengers. Ital J Gastroenterol. 1990 Oct;22(5):283-7.